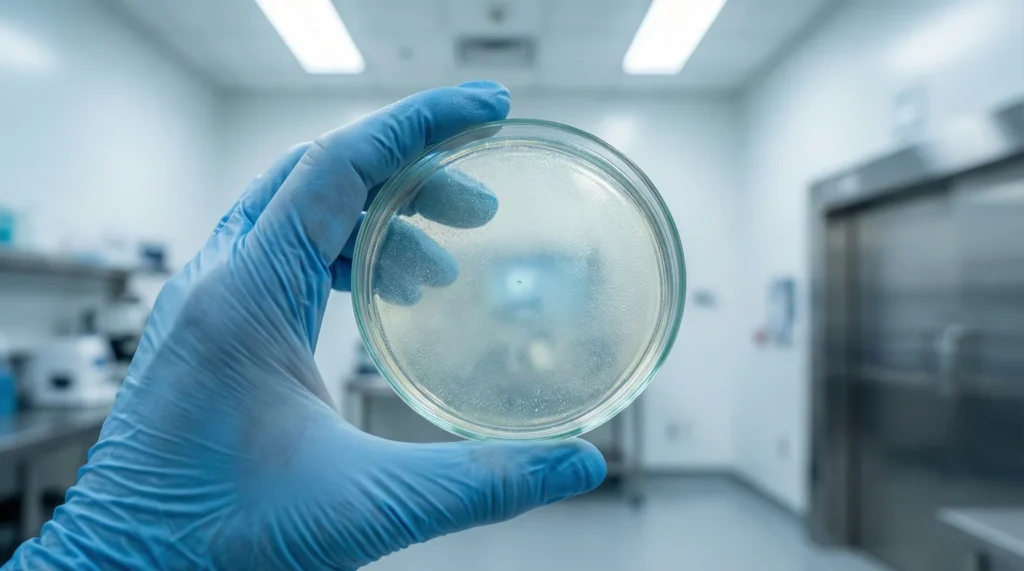
GRAS

Bacillus Coagulans Probiotic Benefits in Prime Biome!
Bacillus coagulans is a well-studied probiotic strain. It is used for gut support, not trends. It stands out because it is spore-forming, so it can handle stomach acid and still reach the gut. That stability is a key reason Prime Biome includes it in a probiotic gummy.
Bacillus coagulans is best known for digestive comfort support, including bloating and irregularity, in human studies.
What Is Bacillus Coagulans?
Bacillus coagulans is a probiotic strain that can form a protective spore. That spore helps it survive harsh conditions on the way to the intestines. Once it reaches the gut, it can “wake up” and become active.

This is why many people search for a Bacillus coagulans probiotic when they want something stable and easy to use.
A spore-forming probiotic explained simply
Spore-forming means the probiotic can go into a “sleep mode.” In that state, it has a tough outer coat. That coat helps it handle heat, time on the shelf, and stomach acid.
Many probiotic strains are more fragile. Some may lose strength in storage. Some may struggle in strong stomach acid. Spore-forming strains are built to be more steady.
This is also why you will hear Bacillus coagulans described as acid-resistant and heat-stable. Those traits support better delivery.
How Bacillus coagulans works in the gut
After the spore survives the stomach, it can germinate in the intestines. Germination means it becomes active again. It then interacts with the gut environment during transit.
A key point is temporary colonization. Many probiotics do not “move in forever.” They can still help while they pass through. That is one reason daily use is common.
Bacillus coagulans is also studied for links to gut motility and comfort. Motility is the normal movement of food through the gut. When that rhythm feels smoother, people often report less heaviness, less gas, and better stool form.

Bacillus coagulans is a spore-forming probiotic that survives digestion and activates in the gut.
Clinical Evidence for IBS and Digestion
Human research matters most here. Bacillus coagulans has been studied in controlled trials for digestive comfort, including symptoms that overlap with IBS, like bloating and abdominal discomfort. Evidence does not mean a cure. It means the strain has been tested with measurable outcomes.
Also, probiotic results can vary by strain. So it helps to look for strain-specific research, not just “probiotics” in general.

Research on IBS-D and bloating
IBS-D means diarrhea-predominant irritable bowel syndrome. In trials, some Bacillus coagulans strains have been linked to improvements in symptoms like gas, bloating, and discomfort compared with placebo. These studies often track stool pattern, pain scores, and quality-of-life measures.
A careful way to say it is this: some clinical studies suggest Bacillus coagulans may help support digestive comfort in IBS-type symptoms, especially bloating and stool irregularity, depending on the strain and dose.
That is also why “IBS-D” shows up in the semantic cluster for this ingredient page. It is a common research area for this strain.
Gut motility and digestive comfort
Gut motility is the “pace” of digestion. When the pace is off, people may feel urgency, cramping, or stuck. Some probiotic research looks at comfort outcomes tied to that rhythm, such as stool form and frequency.
Probiotics do not act like a laxative or stimulant. They work more like a slow “tune up” of an ecosystem. That is why daily use and steady timing are common in studies.
Bacillus coagulans may support digestion comfort by helping the gut environment stay more balanced during daily transit.
CFU dosage and effectiveness
CFU means “colony forming units.” It is a way to count viable microbes. People often assume more CFU is always better. That is not always true.
What matters is strain specificity, survival rate, and whether the dose matches human trials. A lower CFU that survives well can be more useful than a very high CFU that dies before it reaches the gut.
Spore-forming survival is a big reason Bacillus coagulans is used. It can help the dose stay meaningful through digestion.
CFU counts matter, but strain type and survival matter just as much as the number.
Clinical studies show Bacillus coagulans may support digestion and reduce bloating, especially in IBS-D, depending on strain and dose.
Safety Profile of Bacillus Coagulans
Safety questions are normal. Most healthy adults tolerate probiotics well in trials, but risks depend on the person and the context. Large reviews of probiotic safety report low overall risk in healthy groups, while noting rare issues in high-risk groups.
Bacillus coagulans is generally described as non-pathogenic when used as a probiotic strain.
General safety and tolerance
In research settings, probiotics are usually linked to mild and temporary side effects, mainly digestive. Large reviews note that serious issues are rare in healthy people, though reporting can vary by study.
Bacillus coagulans also shows up in U.S. regulatory pathways through GRAS notices for specific strains used in foods and supplements. GRAS status is strain-specific, so it is not a blanket label for all forms of “Bacillus.”
Bacillus coagulans is considered safe for most healthy adults when used as directed, with mild digestive effects being the most common.
Who should be cautious
Some people should use probiotics only with medical guidance. This includes:
- People who are immunocompromised
- People who recently had major surgery
- People with central lines or severe illness
Safety reviews describe theoretical risks such as systemic infection in vulnerable groups, mostly reported in case reports, not typical users.
This is not meant to scare anyone. It is basic risk screening. It is also why “risk group” is part of the entity map for a YMYL ingredient page.
Common mild reactions
The most common early reactions to probiotics are:
- Temporary gas
- Mild bloating
- A short “adjustment phase”
This can happen when the microbiome shifts. Many people notice it fades as the gut adapts, often within days to a couple of weeks.
If symptoms feel strong, last long, or come with fever or blood in stool, that is not a normal adjustment sign. That is a reason to stop and get medical help.
Why Prime Biome Uses This Strain
Prime Biome does not use Bacillus coagulans to look fancy on a label. It is used because it fits how people actually take probiotics in real life: daily, on busy schedules, with meals that vary.
In product testing and customer feedback loops, stability and tolerance matter as much as the ingredient list.

Prime Biome uses Bacillus coagulans for its stability, safety profile, and digestion-focused research.
Stability and delivery advantages
Bacillus coagulans is spore-forming. That means it can be more stable during storage and better able to survive stomach acid. Those traits support consistent delivery.
A gummy format also benefits from stable strains. Gummies sit at room temp in many homes. A strain that is more heat-stable and shelf-stable helps keep quality more reliable.
Prime Biome is also made in an FDA-registered facility and is third-party tested. Those are quality signals tied to trust, not hype.
Alignment with Prime Biome’s gut-support goals
Prime Biome is designed as a daily supplement for gut microbiome support. The goal is gentle daily balance, not a hard “flush” or stimulant.
Bacillus coagulans fits that goal because it is not used as a quick “feel it now” ingredient. It is used as a steady support tool, the way many probiotic studies are structured.
Prime Biome is also vegan, gluten-free, and non-GMO, which matters for many users who screen for dietary fit.
Synergy with other Prime Biome ingredients
A probiotic formula works best when it supports the whole microbiome environment. Bacillus coagulans can be part of that because it is designed to survive digestion and become active in the gut.
It also tends to “play well” in formulas meant for steady use. In plain words, it supports balance without acting like a stimulant.

FAQs About Bacillus Coagulans Probiotic
What makes Bacillus coagulans different from other probiotics?
Bacillus coagulans is different because it is spore-forming, which helps it survive stomach acid and stay more stable in storage than many fragile strains.
Is Bacillus coagulans good for IBS?
Some human studies suggest certain Bacillus coagulans strains may support digestive comfort in IBS-type symptoms like bloating and stool irregularity. It is not a cure, and results depend on strain and dose.
How long does Bacillus coagulans take to work?
Many probiotic studies measure changes over 2 to 8 weeks. Some people notice early comfort changes sooner, but most benefits are tracked with consistent daily use over time.
Can Bacillus coagulans cause side effects?
Yes, mild side effects can happen, especially early on. The most common are gas and bloating during the adjustment phase. Serious risks are rare in healthy adults but may be higher in immunocompromised users.
Why is Bacillus coagulans used in Prime Biome?
Prime Biome uses Bacillus coagulans because it is stable, spore-forming, and backed by human research for digestion comfort. It also fits a daily probiotic gummy format with steady delivery.
Final Takeaway — A Gentle, Science-Backed Probiotic Strain
Bacillus coagulans is not a “trend” probiotic. It is a science-backed strain with a key practical advantage: spore-forming stability. That stability supports gut survival, which is a basic requirement for any probiotic to have a fair shot at helping.

Human studies suggest it may support digestion comfort, including bloating and stool pattern outcomes in IBS-type symptoms, depending on strain and dose.
Safety reviews of probiotics overall show low risk for healthy users, with added caution for high-risk groups.
If the next step is learning more, the most useful path is simple: explore the full Prime Biome ingredient logic, review the research basics, and match the product to real needs and dietary fit.





